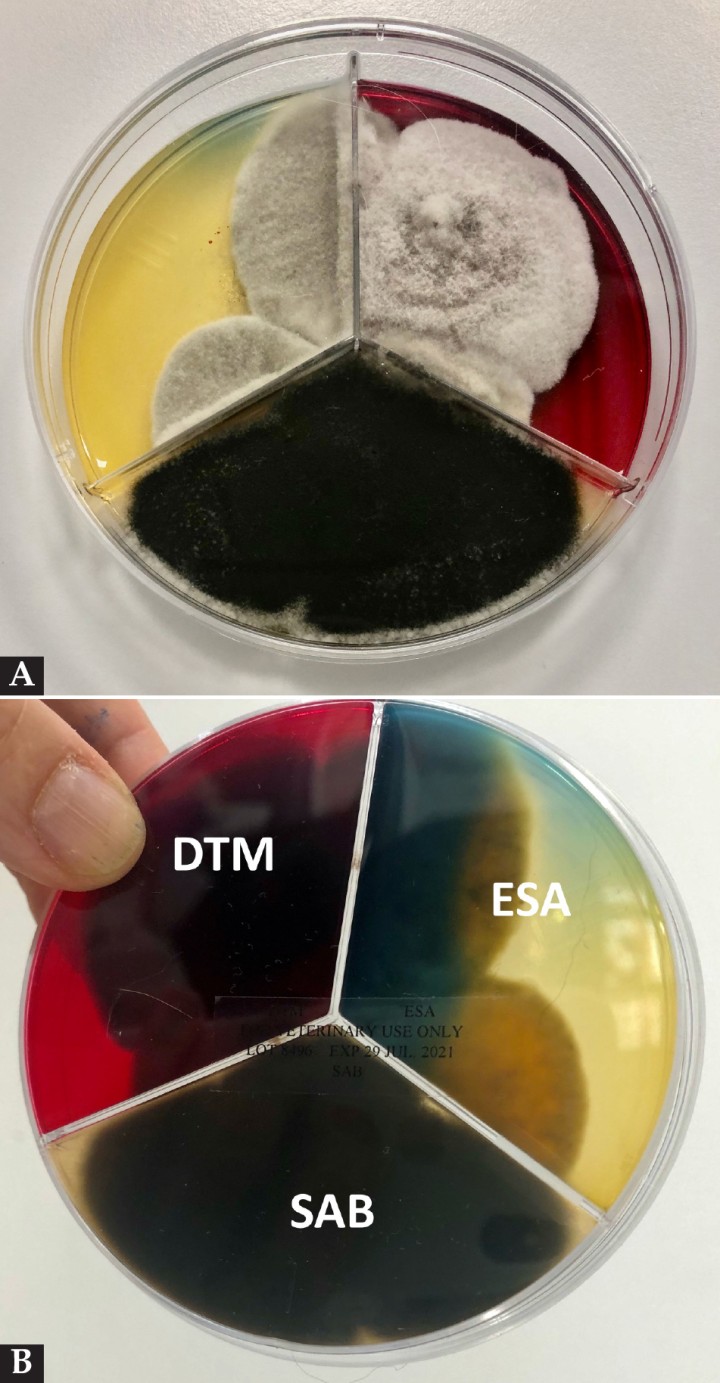
<p>(<strong>A</strong>) Imagen de la placa de Petri con medios para crecimiento fúngico: Sabouraud (SAB)/ medio para dermatofitos (DTM) y agar estimulante de la esporulación (ESA), obtenido de las lesiones faciales y con crecimiento a los 7 días de colonias gris-negro oscuro. (<strong>B</strong>) Reverso de la misma placa con presencia de colonias en los diferentes medios para crecimiento fúngico: SAB/ DTM/ ESA.</p>

Resumen
Alternaria spp. puede causar micosis oportunistas en la piel a través de la inoculación cutánea o mediante diseminación sanguínea en pacientes inmunosuprimidos. Describimos un caso de infección cutánea por Alternaria spp. en un perro mestizo de 2 años que presentaba úlceras, costras y despigmentación en la piel distal de las extremidades, plano y puente nasal, cavidad oral y almohadillas. El perro se encontraba en tratamiento por una poliartritis inmunomediada con dosis inmunosupresoras de prednisolona y leflunomida desde hacía aproximadamente 3 meses. El diagnóstico se basó en los signos clínicos, la demostración de la presencia de estructuras fúngicas en la citología, el cultivo fúngico y la muestra histológica. Se obtuvo la remisión clínica completa con el tratamiento con itraconazol oral y la interrupción del tratamiento inmunosupresor.
Abstract
Alternaria spp. may cause opportunistic mycoses in the skin after cutaneous inoculation or through blood dissemination in immunosuppressed patients. We describe a case of cutaneous infection with Alternaria spp. in a 2 year-old mongrel male dog presenting with multiple ulcers, crusts and skin depigmentation in the distal limbs, nasal plane, bridge of the nose, oral cavity, and paws. The dog had been receiving treatment for immune-mediated polyarthritis with immunosuppressive doses of prednisolone and leflunomide for approximately 3 months. The diagnosis was based on clinical signs, demonstration of fungal elements in the skin cytology, biopsies, and deep fungal culture. Complete clinical remission was achieved by oral treatment with itraconazole and cessation of immunosuppressive medication.

La presencia de este logo en un artículo de la revista indica que se publicará un examen sobre el mismo en la plataforma AVEPA Elearning. Su resolución aporta 0,15 créditos dentro del sistema de acreditaciones de especialidades veterinarias de AVEPA.
Introducción
Las infecciones por hongos oportunistas invasivos son un problema emergente en medicina humana y veterinaria.[ Classen J, Dengler B, Klinger CJ, et al. Cutaneous alternariosis in an immunocompromised dog successfully treated with cold plasma and cessation of immunosuppressive medication. Tierarztl Prax Ausgabe K Kleintiere - Heimtiere 2017; 45(5): 337-343. [PubMed] ] En personas la mayoría están causadas por Candida o Aspergillus siendo otro tipo de hongos oportunistas mucho menos frecuentes.[ McAtee BB, Cummings KJ, Cook AK, et al. Opportunistic invasive cutaneous fungal infections associated with administration of cyclosporine to dogs with immune-mediated disease. J Vet Intern Med 2017; 31(6): 1724-1729. [PubMed] ] Dentro de este último grupo se encuentran las feohifomicosis y las hialohifomicosis.[ Seyedmousavi S, Guillot J, de Hoog GS. Phaeohyphomycoses, emerging opportunistic diseases in animals. Clin Microbiol Rev 2013; 26(1): 19-35. [PubMed] ]
Se denominan feohifomicosis aquellas infecciones causadas por hongos con pigmento en su pared celular, a diferencia de los hongos no pigmentados que causan las hialohifomicosis.[ Seyedmousavi S, Guillot J, de Hoog GS. Phaeohyphomycoses, emerging opportunistic diseases in animals. Clin Microbiol Rev 2013; 26(1): 19-35. [PubMed] ] Las especies de hongos que con mayor frecuencia producen feohifomicosis son las pertenecientes a los géneros Alternaria, Exophiala, Phialophora y Wangiella.[ Classen J, Dengler B, Klinger CJ, et al. Cutaneous alternariosis in an immunocompromised dog successfully treated with cold plasma and cessation of immunosuppressive medication. Tierarztl Prax Ausgabe K Kleintiere - Heimtiere 2017; 45(5): 337-343. [PubMed] , Seyedmousavi S, Guillot J, de Hoog GS. Phaeohyphomycoses, emerging opportunistic diseases in animals. Clin Microbiol Rev 2013; 26(1): 19-35. [PubMed] ] Alternaria spp. es un hongo pigmentado distribuido en todo el mundo, con cientos de especies y que se encuentra en el suelo o las plantas.[ McAtee BB, Cummings KJ, Cook AK, et al. Opportunistic invasive cutaneous fungal infections associated with administration of cyclosporine to dogs with immune-mediated disease. J Vet Intern Med 2017; 31(6): 1724-1729. [PubMed] ] Es también abundante en la piel del perro y forma parte de su microbiota.[ Classen J, Dengler B, Klinger CJ, et al. Cutaneous alternariosis in an immunocompromised dog successfully treated with cold plasma and cessation of immunosuppressive medication. Tierarztl Prax Ausgabe K Kleintiere - Heimtiere 2017; 45(5): 337-343. [PubMed] ]
La inmunidad celular juega un papel crucial en la protección frente a los agentes fúngicos. Se ha descrito que los factores que predisponen en personas a padecer infecciones por hongos oportunistas incluyen enfermedades debilitantes, tratamientos en unidades de cuidados intensivos, ventilación mecánica, medicación inmunosupresora, pacientes con hiperadrenocorticismo, infección por el virus de la inmunodeficiencia humana, diabetes mellitus o receptores de órganos.[ Classen J, Dengler B, Klinger CJ, et al. Cutaneous alternariosis in an immunocompromised dog successfully treated with cold plasma and cessation of immunosuppressive medication. Tierarztl Prax Ausgabe K Kleintiere - Heimtiere 2017; 45(5): 337-343. [PubMed] , McAtee BB, Cummings KJ, Cook AK, et al. Opportunistic invasive cutaneous fungal infections associated with administration of cyclosporine to dogs with immune-mediated disease. J Vet Intern Med 2017; 31(6): 1724-1729. [PubMed] , Seyedmousavi S, Guillot J, de Hoog GS. Phaeohyphomycoses, emerging opportunistic diseases in animals. Clin Microbiol Rev 2013; 26(1): 19-35. [PubMed] , Brás S, Sabino R, Laureano A, et al. Cutaneous infection by different Alternaria species in a liver transplant recipient. Med Mycol Case Rep 2015; 8:1-4. [PubMed] , Dedola C, Stuart APG, Ridyard AE, et al. Cutaneous Alternaria infectoria infection in a dog in association with therapeutic immunosuppression for the management of immune-mediated haemolytic anaemia. Vet Dermatol 2010; 21(6): 626-634. [PubMed] , Pastor FJ, Guarro J. Alternaria infections: Laboratory diagnosis and relevant clinical features. Clin Microbiol Infect 2008; 14(8): 734-746. [PubMed] ]
En este trabajo describimos un caso de infección cutánea y subcutánea por Alternaria spp. en un perro que se encontraba en tratamiento inmunosupresor con prednisolona y leflunomida por una poliartritis inmunomediada.
Caso clínico
Perro macho castrado de raza mestiza de 2 años y 18 kg de peso que acudió a consulta de dermatología por lesiones cutáneas de 2 meses de evolución que no mejoraban con tratamiento tópico antiséptico. Las lesiones aparecieron como heridas en las extremidades anteriores, cara y almohadillas. El animal se lamía las lesiones, pero no presentaba cojeras.
El perro había sido remitido al servicio de medicina interna del hospital 3 meses antes por un cuadro de poliartritis que había aparecido 10 días después de la vacuna de la rabia. Se le habían realizado pruebas para descartar enfermedades infecciosas como cultivo bacteriano del líquido articular, determinación de anticuerpos en sangre mediante inmunofluorescencia indirecta frente a leishmaniosis, prueba rápida ELISA frente a Anaplasma spp., Borrelia burgdorferi, Ehrlichia spp. y Dirofilaria immitis (SNAP 4Dx Plus IDEXX, Barcelona España), PCR de Mycoplasma y Bartonella en líquido articular y todas ellas habían resultado negativas, por lo que se consideró un diagnóstico por exclusión de poliartritis inmunomediada. El perro se encontraba en tratamiento con dosis inmunosupresoras y decrecientes de glucocorticoides y leflunomida desde hacía 3 meses. En el momento de la consulta estaba tomando desde hacía 3 semanas leflunomida en una dosis de 10 mg cada 24 h VO (Leflunomida Cinfa® 10 mg comprimidos Laboratorios Cinfa, S.A, Huarte, Navarra, España) y prednisona en una dosis de 15 mg VO por la mañana y 7,5 mg VO por las noches (Prednisona Kern Pharma® 30 mg comprimidos, Kern Pharma, S.L, Terrassa, Barcelona, España).
Dos meses después de comenzar el tratamiento inmunosupresor aparecieron las lesiones alopécicas en extremidades y posteriormente las lesiones en la cara. Las últimas lesiones en aparecer habían sido en las almohadillas.
Las lesiones cutáneas habían sido tratadas con ozono inyectable, aloe vera, clorhexidina, urea y centella asiática, sin mejoría. El estado general del paciente era bueno y no presentaba otros signos clínicos.
A la exploración, el perro presentaba atrofia muscular generalizada y constantes normales.
A nivel dermatológico, presentaba lesiones erosivo-ulcerativas, costrosas, alopécicas y despigmentadas en la unión puente-plano nasal, con conservación de la arquitectura de la trufa (Fig. 1). Presentaba alopecias focales con leve eritema en extremidades anteriores y úlceras en la piel interdigital y en la unión piel interdigital-cojinetes de las 4 extremidades (Figs. 2 y 3). En estas lesiones había eritema, exudación y dolor a la exploración. Algunas almohadillas mostraban despigmentación (Fig. 3B). Se observaron también úlceras en paladar duro y lengua (Fig. 4).




Se tomaron muestras para el examen microscópico del pelo de las zonas alopécicas y muestras por impresión de las lesiones más inflamadas de una extremidad posterior y de una úlcera en puente nasal. El examen microscópico de la estructura del pelo fue normal, con predominio de bulbos en fase de telogén, no observándose agentes infecciosos.
Las citologías fueron teñidas con una tinción modificada de Wright/Giemsa (Quick Panoptic®, Química Aplicada SA, Tarragona, España). En la secreción de las lesiones de extremidades posteriores se observó una inflamación neutrofílica y macrofágica con presencia de escasas bacterias (cocos) intra y extracelulares. En la citología de la lesión ulcerativa del puente nasal se observó inflamación neutrofílica y macrofágica con estructuras compatibles con microorganismos en forma de levadura de gran tamaño en gemación, e hifas o pseudohifas fúngicas (Fig. 5).

Se tomaron muestras tisulares de las lesiones cutáneas bajo anestesia general y utilizando punch de biopsia desechable de 6 y 4 mm (Disposable biopsy punch®, Kai Europe, GmbH Solingen, Alemania) en el puente nasal, extremidades y unión piel-cojinetes plantares para cultivo bacteriano y estudio histopatológico. Se obtuvieron también muestras de las lesiones faciales tisulares y del exudado para cultivo fúngico en placa de Petri con medio Sabouraud (SAB), medio para dermatofitos (DTM) y agar estimulante de la esporulación (ESA) (Dermatophyte Test Petri dish®, Henry Schein España S.A, Madrid, España). Se tomaron muestras para citología por impronta de las lesiones ulcerativas de lengua y paladar, donde se observó una población mixta de bacterias en ausencia de células inflamatorias.
Los análisis de sangre de control revelaron leucocitosis (21 240/mm3; ref: 6-17x103/mm3) con neutrofilia (19 030/mm3; ref: 3,62-12,3x103/mm3) y trombocitosis (609 000/mm3; ref: 117-490x103/mm3). Se observó un aumento de la alanina aminotransferasa (ALT) con valores de 665 UI/l (ref: 9-60 UI/l), fosfatasa alcalina (FA) 2317 UI/l (ref: 107-120 UI/l), gamma-glutamiltransferasa (GGT) 915 UI/l (ref: 3-9 UI/l), colesterol 641 mg/dl (ref: 125-310 mg/dl) y fósforo 5,6 mg/dl (ref: 3,0-4,5 mg/dl).
La ecografía abdominal mostró hepatomegalia leve compatible con hepatopatía esteroidea. Se tomó una muestra ecoguiada del hígado para citología. La citología hepática reveló una marcada degeneración vacuolar. Se realizó un diagnóstico provisional de hepatopatía esteroidea secundaria al tratamiento con glucocorticoides e infección fúngica y bacteriana cutánea y subcutánea secundaria al tratamiento inmunosupresor. Mientras se esperaban los resultados de las pruebas pendientes, se le retiró la leflunomida oral y se mantuvo la dosis de prednisona a 20 mg cada 24 h VO. Se le instauró un tratamiento con ácido fusídico tópico (Fucidine 20 mg/g pomada, Laboratorio Leo Pharma S.A, Barcelona, España) e intraconazol oral, 5 mg/kg VO cada 24 h (Canadiol® 100 mg cápsulas, Esteve Pharmaceutical, S.A, Barcelona, España) a semanas alternas hasta los resultados.
El estudio histológico obtuvo resultados similares en todas las muestras cutáneas. La epidermis mostraba hiperplasia irregular con hiperqueratosis ortoqueratótica y, en la muestra correspondiente a la nariz, se apreciaba una amplia ulceración. La dermis superficial, en especial la zona interfolicular, presentaba un infiltrado inflamatorio denso con predominio de macrófagos, junto con algunos polinucleares neutrófilos y focos linfoplasmocíticos en los que se observaban formaciones esféricas y filamentosas compatibles con formas fúngicas (hifas segmentadas y no pigmentadas). Las tinciones de Grocott y PAS resultaron positivas. El diagnóstico fue de una dermatitis piogranulomatosa de etiología fúngica (feohifomicosis, hialohifomicosis o micosis subcutánea) (Figs. 6-8).



En el cultivo fúngico crecieron de forma rápida (5-7 días) abundantes colonias de color gris-negro oscuro (Fig. 9). En el examen microscópico se observaron hifas septadas y macroconidios de color marrón, cilíndricos con ramas o septos transversos y oblicuos característicos de Alternaria spp. (Fig. 10). En el cultivo bacteriano crecieron, tras enriquecimiento, escasas colonias de Streptococcus betahemolítico sensible a todos los antibióticos probados. De acuerdo con los resultados se estableció un diagnóstico de alternariosis cutánea asociada a inmunosupresión y se mantuvo el tratamiento con itraconazol oral hasta revisión.

En la revisión del paciente a los 15 días tras empezar el tratamiento, el estado general era bueno y había tolerado bien la medicación. Las lesiones cutáneas faciales presentaban menor exudación y se encontraban en vías de epitelización (Fig. 11). Las úlceras en los cojinetes habían mejorado, pero no tan evidentemente. El perro se lamía las lesiones a las que tenía acceso.

Se realizó un control analítico con los siguientes resultados alterados: fosfatasa alcalina (FA) 3278 UI/l (ref: 25-190 UI/l) gamma-glutamiltransferasa (GGT) 1171 UI/l (ref: 3-9 UI/l) y alanina aminotransferasa (ALT) 626 UI/l ref: 9-60 UI/l). Debido al marcado aumento de las enzimas hepáticas, la tutora declinó continuar el tratamiento con itraconazol oral, estableciéndose una pauta de disminución progresiva de la administración de prednisona oral.
El día 33 tras el inicio del tratamiento se estableció contacto telefónico y la tutora nos informó de que las lesiones cutáneas estaban resueltas.
Discusión
Alternaria spp. causa micosis oportunista en la piel después de la inoculación cutánea o a través de diseminación sanguínea en personas inmunocomprometidas, pudiendo provocar infección cutánea y subcutánea (74,3 %), oculomicosis (9,5 %), rinosinusitis invasiva y no invasiva (8,1 %) y onicomicosis (8,1 %), o provocar una infección diseminada que puede tener una evolución fatal.[ Pastor FJ, Guarro J. Alternaria infections: Laboratory diagnosis and relevant clinical features. Clin Microbiol Infect 2008; 14(8): 734-746. [PubMed] , Satta R, Dore MP, Pes GM, Biondi G. Iatrogenic immunosuppression may favour Alternaria skin lesion flares. BMJ Case Rep 2018; 2018: 2017-2019. [PubMed] ] La alternariosis se considera una infección invasiva, ya que penetra en los tejidos a diferencia de infecciones localizadas no invasivas como la aspergilosis nasal.[ McAtee BB, Cummings KJ, Cook AK, et al. Opportunistic invasive cutaneous fungal infections associated with administration of cyclosporine to dogs with immune-mediated disease. J Vet Intern Med 2017; 31(6): 1724-1729. [PubMed] ]
Las publicaciones de infecciones por hongos pigmentados en animales de sangre caliente han sido escasas y se describen como cuadros clínicos con afectación neurológica principalmente.[ Classen J, Dengler B, Klinger CJ, et al. Cutaneous alternariosis in an immunocompromised dog successfully treated with cold plasma and cessation of immunosuppressive medication. Tierarztl Prax Ausgabe K Kleintiere - Heimtiere 2017; 45(5): 337-343. [PubMed] ] Sin embargo, en la última década las infecciones por hongos oportunistas se han convertido en un problema de salud emergente tanto en medicina humana como veterinaria.[ Classen J, Dengler B, Klinger CJ, et al. Cutaneous alternariosis in an immunocompromised dog successfully treated with cold plasma and cessation of immunosuppressive medication. Tierarztl Prax Ausgabe K Kleintiere - Heimtiere 2017; 45(5): 337-343. [PubMed] , McAtee BB, Cummings KJ, Cook AK, et al. Opportunistic invasive cutaneous fungal infections associated with administration of cyclosporine to dogs with immune-mediated disease. J Vet Intern Med 2017; 31(6): 1724-1729. [PubMed] , Seyedmousavi S, Guillot J, de Hoog GS. Phaeohyphomycoses, emerging opportunistic diseases in animals. Clin Microbiol Rev 2013; 26(1): 19-35. [PubMed] , Brás S, Sabino R, Laureano A, et al. Cutaneous infection by different Alternaria species in a liver transplant recipient. Med Mycol Case Rep 2015; 8:1-4. [PubMed] , Dedola C, Stuart APG, Ridyard AE, et al. Cutaneous Alternaria infectoria infection in a dog in association with therapeutic immunosuppression for the management of immune-mediated haemolytic anaemia. Vet Dermatol 2010; 21(6): 626-634. [PubMed] , Pastor FJ, Guarro J. Alternaria infections: Laboratory diagnosis and relevant clinical features. Clin Microbiol Infect 2008; 14(8): 734-746. [PubMed] , Satta R, Dore MP, Pes GM, Biondi G. Iatrogenic immunosuppression may favour Alternaria skin lesion flares. BMJ Case Rep 2018; 2018: 2017-2019. [PubMed] , Demirci M, Baran N, Uzum A, et al. Cutaneous alternariasis in a patient with renal transplant. Jundishapur J Microbiol 2015; 8(5): 1-3. [PubMed] , Fondati A, Gallo MG, Romano E, Fondevila D. A case of feline phaeohyphomycosis due to Fonsecaea pedrosoi. Vet Dermatol 2001; 12(5): 297-301. [PubMed] ]
En personas la alternariosis puede estar causada por heridas penetrantes o abrasiones en la piel y se asocia a profesiones en contacto con el suelo, como agricultores y jardineros, o bien, de forma más frecuente, como infecciones oportunistas asociadas a pacientes inmunocomprometidos, principalmente trasplantados, con síndrome de Cushing o en tratamiento con prednisona, siendo Alternaria alternata y A. infectoria las especies más frecuentemente aisladas.[ Classen J, Dengler B, Klinger CJ, et al. Cutaneous alternariosis in an immunocompromised dog successfully treated with cold plasma and cessation of immunosuppressive medication. Tierarztl Prax Ausgabe K Kleintiere - Heimtiere 2017; 45(5): 337-343. [PubMed] , McAtee BB, Cummings KJ, Cook AK, et al. Opportunistic invasive cutaneous fungal infections associated with administration of cyclosporine to dogs with immune-mediated disease. J Vet Intern Med 2017; 31(6): 1724-1729. [PubMed] , Seyedmousavi S, Guillot J, de Hoog GS. Phaeohyphomycoses, emerging opportunistic diseases in animals. Clin Microbiol Rev 2013; 26(1): 19-35. [PubMed] , Brás S, Sabino R, Laureano A, et al. Cutaneous infection by different Alternaria species in a liver transplant recipient. Med Mycol Case Rep 2015; 8:1-4. [PubMed] , Demirci M, Baran N, Uzum A, et al. Cutaneous alternariasis in a patient with renal transplant. Jundishapur J Microbiol 2015; 8(5): 1-3. [PubMed] ]
En animales de compañía se ha descrito que la especie felina es más susceptible de sufrir feohifomicosis que otros carnívoros.[ Fondati A, Gallo MG, Romano E, Fondevila D. A case of feline phaeohyphomycosis due to Fonsecaea pedrosoi. Vet Dermatol 2001; 12(5): 297-301. [PubMed] , Miller RI. Nodular granulomatous fungal skin diseases of cats in the United Kingdom: A retrospective review. Vet Dermatol 2010; 21(2): 130-135. [PubMed] ] En un estudio realizado en lesiones nodulares piogranulomatosas en 77 gatos en el Reino Unido, el 89 % de las lesiones estaban causadas por hialohifomicosis y feohifomicosis y solo un 11 % eran pseudomicetomas dermatofíticos, de lo cual se concluyó que la alternariosis era la causa más frecuente de infecciones fúngicas cutáneas en gatos en el Reino Unido.[ Miller RI. Nodular granulomatous fungal skin diseases of cats in the United Kingdom: A retrospective review. Vet Dermatol 2010; 21(2): 130-135. [PubMed] ] En la especie felina no parece haber predilección de sexo o raza y se asume que la infección está provocada por heridas penetrantes que se localizan sobre todo en el área facial y extremidades.[ Miller RI. Nodular granulomatous fungal skin diseases of cats in the United Kingdom: A retrospective review. Vet Dermatol 2010; 21(2): 130-135. [PubMed] ]
En la especie canina existen escasas publicaciones de infecciones por hongos cutáneos invasivos oportunistas y se han descrito principalmente en perros con enfermedades inmunomediadas y con tratamiento inmunosupresor, representando una complicación importante en esta población.[ Classen J, Dengler B, Klinger CJ, et al. Cutaneous alternariosis in an immunocompromised dog successfully treated with cold plasma and cessation of immunosuppressive medication. Tierarztl Prax Ausgabe K Kleintiere - Heimtiere 2017; 45(5): 337-343. [PubMed] , McAtee BB, Cummings KJ, Cook AK, et al. Opportunistic invasive cutaneous fungal infections associated with administration of cyclosporine to dogs with immune-mediated disease. J Vet Intern Med 2017; 31(6): 1724-1729. [PubMed] , Dedola C, Stuart APG, Ridyard AE, et al. Cutaneous Alternaria infectoria infection in a dog in association with therapeutic immunosuppression for the management of immune-mediated haemolytic anaemia. Vet Dermatol 2010; 21(6): 626-634. [PubMed] ] Las condiciones inmunomediadas que han sido descritas asociadas a la infección son: anemia, trombocitopenia y poliartritis inmunomediada, síndrome de Evans y enfermedad inflamatoria intestinal.[ Classen J, Dengler B, Klinger CJ, et al. Cutaneous alternariosis in an immunocompromised dog successfully treated with cold plasma and cessation of immunosuppressive medication. Tierarztl Prax Ausgabe K Kleintiere - Heimtiere 2017; 45(5): 337-343. [PubMed] , McAtee BB, Cummings KJ, Cook AK, et al. Opportunistic invasive cutaneous fungal infections associated with administration of cyclosporine to dogs with immune-mediated disease. J Vet Intern Med 2017; 31(6): 1724-1729. [PubMed] , Dedola C, Stuart APG, Ridyard AE, et al. Cutaneous Alternaria infectoria infection in a dog in association with therapeutic immunosuppression for the management of immune-mediated haemolytic anaemia. Vet Dermatol 2010; 21(6): 626-634. [PubMed] ] Los medicamentos inmunosupresores asociados a esta infección han sido uno o más de los siguientes: glucocorticoides, ciclosporina, azatioprina, clorambucilo, micofenolato de mofetilo y leflunomida, atribuyéndose en concreto la infección por Alternaria principalmente al tratamiento con ciclosporina.[ Classen J, Dengler B, Klinger CJ, et al. Cutaneous alternariosis in an immunocompromised dog successfully treated with cold plasma and cessation of immunosuppressive medication. Tierarztl Prax Ausgabe K Kleintiere - Heimtiere 2017; 45(5): 337-343. [PubMed] , McAtee BB, Cummings KJ, Cook AK, et al. Opportunistic invasive cutaneous fungal infections associated with administration of cyclosporine to dogs with immune-mediated disease. J Vet Intern Med 2017; 31(6): 1724-1729. [PubMed] , Dedola C, Stuart APG, Ridyard AE, et al. Cutaneous Alternaria infectoria infection in a dog in association with therapeutic immunosuppression for the management of immune-mediated haemolytic anaemia. Vet Dermatol 2010; 21(6): 626-634. [PubMed] ]
En la especie canina todos los casos descritos en la literatura científica tienen una presentación exclusivamente cutánea y subcutánea.[ Classen J, Dengler B, Klinger CJ, et al. Cutaneous alternariosis in an immunocompromised dog successfully treated with cold plasma and cessation of immunosuppressive medication. Tierarztl Prax Ausgabe K Kleintiere - Heimtiere 2017; 45(5): 337-343. [PubMed] , McAtee BB, Cummings KJ, Cook AK, et al. Opportunistic invasive cutaneous fungal infections associated with administration of cyclosporine to dogs with immune-mediated disease. J Vet Intern Med 2017; 31(6): 1724-1729. [PubMed] , Dedola C, Stuart APG, Ridyard AE, et al. Cutaneous Alternaria infectoria infection in a dog in association with therapeutic immunosuppression for the management of immune-mediated haemolytic anaemia. Vet Dermatol 2010; 21(6): 626-634. [PubMed] ] En el caso que describimos, aunque el perro vivía en un área rural, no tenía historia de heridas en la piel, pero estaba en tratamiento inmunosupresor con prednisolona y leflunomida aproximadamente 60 días previos a la aparición de las lesiones. No había sido tratado con ciclosporina, pero sí con prednisona oral, coincidiendo con lo descrito en el ser humano en el que el tratamiento inmunosupresor con prednisona o pacientes con síndrome de Cushing son factores determinantes para padecer infecciones por Alternaria u otros hongos oportunistas.[ Brás S, Sabino R, Laureano A, et al. Cutaneous infection by different Alternaria species in a liver transplant recipient. Med Mycol Case Rep 2015; 8:1-4. [PubMed] , Demirci M, Baran N, Uzum A, et al. Cutaneous alternariasis in a patient with renal transplant. Jundishapur J Microbiol 2015; 8(5): 1-3. [PubMed] ] La vía de penetración del hongo suele ser la piel, sobre todo de las extremidades, y la fragilidad cutánea inducida por los glucocorticoides puede ser un cofactor importante, permitiendo la inoculación directa del ambiente.[ Brás S, Sabino R, Laureano A, et al. Cutaneous infection by different Alternaria species in a liver transplant recipient. Med Mycol Case Rep 2015; 8:1-4. [PubMed] , Gomes J, Vilarinho C, Duarte M da L, Brito C. Cutaneous phaeohyphomycosis caused by Alternaria alternata unresponsive to itraconazole treatment. Case Rep Dermatol Med 2011; 2011: 1-3. [PubMed] ] En medicina veterinaria se ha sugerido que el lamido de las heridas por parte de los animales puede favorecer la inoculación del hongo en diferentes localizaciones del cuerpo, sobre todo en extremidades.[ Dedola C, Stuart APG, Ridyard AE, et al. Cutaneous Alternaria infectoria infection in a dog in association with therapeutic immunosuppression for the management of immune-mediated haemolytic anaemia. Vet Dermatol 2010; 21(6): 626-634. [PubMed] ] En nuestro paciente no había historia de trauma, pero sí de lamido, lo que puede explicar las lesiones en extremidades, pero no las faciales.
Las lesiones cutáneas descritas en personas consisten en máculas eritematosas, pápulas violáceas y nódulos ulcerados y costrosos.[ Satta R, Dore MP, Pes GM, Biondi G. Iatrogenic immunosuppression may favour Alternaria skin lesion flares. BMJ Case Rep 2018; 2018: 2017-2019. [PubMed] ] Se localizan en zonas expuestas del cuerpo como la cara dorsal de las manos, dedos, pies, rodillas y área pretibial.[ Satta R, Dore MP, Pes GM, Biondi G. Iatrogenic immunosuppression may favour Alternaria skin lesion flares. BMJ Case Rep 2018; 2018: 2017-2019. [PubMed] ] Rara vez la infección afecta al ojo, senos nasales, uñas o tiene una presentación sistémica.[ Demirci M, Baran N, Uzum A, et al. Cutaneous alternariasis in a patient with renal transplant. Jundishapur J Microbiol 2015; 8(5): 1-3. [PubMed] ]
La distribución en la especie canina es similar y afecta a extremidades, almohadillas y uñas, pero también es muy frecuente la presentación facial y oral.[ Classen J, Dengler B, Klinger CJ, et al. Cutaneous alternariosis in an immunocompromised dog successfully treated with cold plasma and cessation of immunosuppressive medication. Tierarztl Prax Ausgabe K Kleintiere - Heimtiere 2017; 45(5): 337-343. [PubMed] , McAtee BB, Cummings KJ, Cook AK, et al. Opportunistic invasive cutaneous fungal infections associated with administration of cyclosporine to dogs with immune-mediated disease. J Vet Intern Med 2017; 31(6): 1724-1729. [PubMed] , Dedola C, Stuart APG, Ridyard AE, et al. Cutaneous Alternaria infectoria infection in a dog in association with therapeutic immunosuppression for the management of immune-mediated haemolytic anaemia. Vet Dermatol 2010; 21(6): 626-634. [PubMed] ] Las lesiones pueden aparecer en tronco, cara ventral del cuello y en uñas, donde provocan onicorrexis.[ Dedola C, Stuart APG, Ridyard AE, et al. Cutaneous Alternaria infectoria infection in a dog in association with therapeutic immunosuppression for the management of immune-mediated haemolytic anaemia. Vet Dermatol 2010; 21(6): 626-634. [PubMed] ]
En medicina veterinaria, la presentación nodular es más característica de la infección en la especie felina.[ Fondati A, Gallo MG, Romano E, Fondevila D. A case of feline phaeohyphomycosis due to Fonsecaea pedrosoi. Vet Dermatol 2001; 12(5): 297-301. [PubMed] , Miller RI. Nodular granulomatous fungal skin diseases of cats in the United Kingdom: A retrospective review. Vet Dermatol 2010; 21(2): 130-135. [PubMed] ] En el perro las lesiones suelen ser de erosivas a ulcerativas y costrosas.[ Classen J, Dengler B, Klinger CJ, et al. Cutaneous alternariosis in an immunocompromised dog successfully treated with cold plasma and cessation of immunosuppressive medication. Tierarztl Prax Ausgabe K Kleintiere - Heimtiere 2017; 45(5): 337-343. [PubMed] , McAtee BB, Cummings KJ, Cook AK, et al. Opportunistic invasive cutaneous fungal infections associated with administration of cyclosporine to dogs with immune-mediated disease. J Vet Intern Med 2017; 31(6): 1724-1729. [PubMed] , Dedola C, Stuart APG, Ridyard AE, et al. Cutaneous Alternaria infectoria infection in a dog in association with therapeutic immunosuppression for the management of immune-mediated haemolytic anaemia. Vet Dermatol 2010; 21(6): 626-634. [PubMed] ] Las lesiones en la cavidad oral pueden ser proliferativas y en forma de placa.[ Dedola C, Stuart APG, Ridyard AE, et al. Cutaneous Alternaria infectoria infection in a dog in association with therapeutic immunosuppression for the management of immune-mediated haemolytic anaemia. Vet Dermatol 2010; 21(6): 626-634. [PubMed] ] En nuestro caso las lesiones eran eminentemente erosivas y ulcerativas, tanto las observadas en la piel como en la cavidad oral, y cursaban con despigmentación posiblemente debida al proceso inflamatorio subyacente. El agente causal solo fue observado en la citología obtenida de las lesiones faciales, aunque es probable que todas las lesiones fueran debidas a la misma causa. Las úlceras en cavidad bucal también han sido descritas en alternariosis cutánea canina, pero no se pudo evidenciar la presencia del hongo en las lesiones.[ Dedola C, Stuart APG, Ridyard AE, et al. Cutaneous Alternaria infectoria infection in a dog in association with therapeutic immunosuppression for the management of immune-mediated haemolytic anaemia. Vet Dermatol 2010; 21(6): 626-634. [PubMed] ]
Alternaria spp. se encuentra comúnmente en el ambiente y en el manto del pelo en perros y gatos por lo que puede ser un contaminante común en las pruebas de laboratorio. El diagnóstico definitivo requiere, por tanto, la demostración de hifas fúngicas en las preparaciones histológicas, aislamiento en cultivo fúngico y, si es posible, análisis PCR para determinar la especie de Alternaria. Es un hongo que crece con colonias pigmentadas, pero no siempre esta pigmentación es evidente en tinciones tisulares con hematoxilina eosina (H&E), como sucedió en este caso, donde los elementos fúngicos eran no pigmentados en los cortes histológicos.[ Dedola C, Stuart APG, Ridyard AE, et al. Cutaneous Alternaria infectoria infection in a dog in association with therapeutic immunosuppression for the management of immune-mediated haemolytic anaemia. Vet Dermatol 2010; 21(6): 626-634. [PubMed] , Miller RI. Nodular granulomatous fungal skin diseases of cats in the United Kingdom: A retrospective review. Vet Dermatol 2010; 21(2): 130-135. [PubMed] ]
Las especies que afectan con mayor frecuencia a los mamíferos son Alternaria infectoria, A. alternata y A. tenuissima, siendo la primera la más frecuente en el ser humano desde el punto de vista clínico.[ Brás S, Sabino R, Laureano A, et al. Cutaneous infection by different Alternaria species in a liver transplant recipient. Med Mycol Case Rep 2015; 8:1-4. [PubMed] , Pastor FJ, Guarro J. Alternaria infections: Laboratory diagnosis and relevant clinical features. Clin Microbiol Infect 2008; 14(8): 734-746. [PubMed] ] Estas especies pueden ser diferenciadas por detalles morfológicos o por técnicas moleculares. Alternaria alternata presenta conidios de color pardo en medio Sabouraud con un pico cilíndrico corto y con cadenas largas y profusamente ramificadas.[ Pastor FJ, Guarro J. Alternaria infections: Laboratory diagnosis and relevant clinical features. Clin Microbiol Infect 2008; 14(8): 734-746. [PubMed] ] Alternaria infectoria presenta conidios más escasos, ya que esta especie esporula con dificultad en medios habituales; los conidios se vuelven casi tubulares y se presentan en cadenas fuertemente ramificadas.[ Brás S, Sabino R, Laureano A, et al. Cutaneous infection by different Alternaria species in a liver transplant recipient. Med Mycol Case Rep 2015; 8:1-4. [PubMed] , Pastor FJ, Guarro J. Alternaria infections: Laboratory diagnosis and relevant clinical features. Clin Microbiol Infect 2008; 14(8): 734-746. [PubMed] ] En el caso descrito, la morfología microscópica del hongo es más sugerente de Alternaria alternata, pero no ha sido posible confirmar la especie del hongo al realizarse la observación microscópica por personal no experto y al carecer de pruebas moleculares debido a la no disponibilidad de esta técnica de identificación en los laboratorios clínicos habituales.
En medicina humana y veterinaria no existen tratamientos estandarizados para las infecciones cutáneas causadas por Alternaria spp.[ Brás S, Sabino R, Laureano A, et al. Cutaneous infection by different Alternaria species in a liver transplant recipient. Med Mycol Case Rep 2015; 8:1-4. [PubMed] ] En la mayoría de los casos y cuando es posible, la disminución o eliminación de los niveles de inmunosupresión suele ser en muchos casos suficiente para resolver las lesiones, aunque se recomienda generalmente cursos largos de itraconazol sistémico.[ Pastor FJ, Guarro J. Alternaria infections: Laboratory diagnosis and relevant clinical features. Clin Microbiol Infect 2008; 14(8): 734-746. [PubMed] ] Se han utilizado diversos fármacos antifúngicos como la anfotericina B, los azoles y la terbinafina, si bien en la actualidad el itraconazol es el medicamento más utilizado debido a su buena tolerancia y efectividad.[ Pastor FJ, Guarro J. Alternaria infections: Laboratory diagnosis and relevant clinical features. Clin Microbiol Infect 2008; 14(8): 734-746. [PubMed] ] En caso de mala respuesta al itraconazol se ha descrito el uso del voriconazol y del posaconazol.[ Gomes J, Vilarinho C, Duarte M da L, Brito C. Cutaneous phaeohyphomycosis caused by Alternaria alternata unresponsive to itraconazole treatment. Case Rep Dermatol Med 2011; 2011: 1-3. [PubMed] ] Otros tratamientos descritos son el uso de cámaras hiperbáricas de oxígeno, cirugía y plasma congelado frío.[ Classen J, Dengler B, Klinger CJ, et al. Cutaneous alternariosis in an immunocompromised dog successfully treated with cold plasma and cessation of immunosuppressive medication. Tierarztl Prax Ausgabe K Kleintiere - Heimtiere 2017; 45(5): 337-343. [PubMed] , Pastor FJ, Guarro J. Alternaria infections: Laboratory diagnosis and relevant clinical features. Clin Microbiol Infect 2008; 14(8): 734-746. [PubMed] ] En nuestro caso, aunque el paciente padecía de hepatopatía esteroidea secundaria al tratamiento inmunosupresor, se decidió el tratamiento con itraconazol por vía oral valorando el riego de posible diseminación sistémica del hongo en un paciente inmunocomprometido. Se decidió la pauta a semanas alternas como medida de precaución de los efectos del itraconazol sobre la funcionalidad hepática. La buena respuesta clínica con solo 9 días de tratamiento con itraconazol oral parece demostrar que la reducción y/o eliminación del tratamiento inmunosupresor es el factor más relevante del tratamiento de estos pacientes.
Fuente de financiación: este trabajo no se ha realizado con fondos comerciales, públicos o privados.
Conflicto de intereses: los autores declaran no tener ningún tipo de conflicto de intereses.
Bibliografía
- [1] Classen J, Dengler B, Klinger CJ, et al. Cutaneous alternariosis in an immunocompromised dog successfully treated with cold plasma and cessation of immunosuppressive medication. Tierarztl Prax Ausgabe K Kleintiere - Heimtiere 2017; 45(5): 337-343. [PubMed]
- [2] McAtee BB, Cummings KJ, Cook AK, et al. Opportunistic invasive cutaneous fungal infections associated with administration of cyclosporine to dogs with immune-mediated disease. J Vet Intern Med 2017; 31(6): 1724-1729. [PubMed]
- [3] Seyedmousavi S, Guillot J, de Hoog GS. Phaeohyphomycoses, emerging opportunistic diseases in animals. Clin Microbiol Rev 2013; 26(1): 19-35. [PubMed]
- [4] Brás S, Sabino R, Laureano A, et al. Cutaneous infection by different Alternaria species in a liver transplant recipient. Med Mycol Case Rep 2015; 8:1-4. [PubMed]
- [5] Dedola C, Stuart APG, Ridyard AE, et al. Cutaneous Alternaria infectoria infection in a dog in association with therapeutic immunosuppression for the management of immune-mediated haemolytic anaemia. Vet Dermatol 2010; 21(6): 626-634. [PubMed]
- [6] Pastor FJ, Guarro J. Alternaria infections: Laboratory diagnosis and relevant clinical features. Clin Microbiol Infect 2008; 14(8): 734-746. [PubMed]
- [7] Satta R, Dore MP, Pes GM, Biondi G. Iatrogenic immunosuppression may favour Alternaria skin lesion flares. BMJ Case Rep 2018; 2018: 2017-2019. [PubMed]
- [8] Demirci M, Baran N, Uzum A, et al. Cutaneous alternariasis in a patient with renal transplant. Jundishapur J Microbiol 2015; 8(5): 1-3. [PubMed]
- [9] Fondati A, Gallo MG, Romano E, Fondevila D. A case of feline phaeohyphomycosis due to Fonsecaea pedrosoi. Vet Dermatol 2001; 12(5): 297-301. [PubMed]
- [10] Miller RI. Nodular granulomatous fungal skin diseases of cats in the United Kingdom: A retrospective review. Vet Dermatol 2010; 21(2): 130-135. [PubMed]
- [11] Gomes J, Vilarinho C, Duarte M da L, Brito C. Cutaneous phaeohyphomycosis caused by Alternaria alternata unresponsive to itraconazole treatment. Case Rep Dermatol Med 2011; 2011: 1-3. [PubMed]
Artículos recomendados
Estas recomendaciones se ofrecen de forma automática.
-
Seguridad y eficacia de dos protocolos de pauta de inducción rápida en el tratamiento con inmunoterapia para la dermatitis atópica canina: estudio piloto
L. Ramió-Lluch, C. Bustillo, A. Dalmau, et al.Clin Vet Peq Anim Vol. 43 - Nº 1 · MAR 2023 · Artículo original referido a múltiples casos clínicos -
Enfermedades infecciosas y parasitarias en anfibios en cautividad: estudio retrospectivo de 131 pacientes
C. Juan-Sallés, V. Almagro, L. Carbonell, et al.Clin Vet Peq Anim Vol. 40 - Nº 1 · MAR 2020 · Artículo original referido a múltiples casos clínicos -
Gastrointestinal stromal tumors (GIST): retrospective study of 6 dogs
I. Montañés, A. Vila, X. Roura, et al.Clin Vet Peq Anim Vol. 39 - Nº 3 · SEP 2019 · Artículo original referido a múltiples casos clínicos


